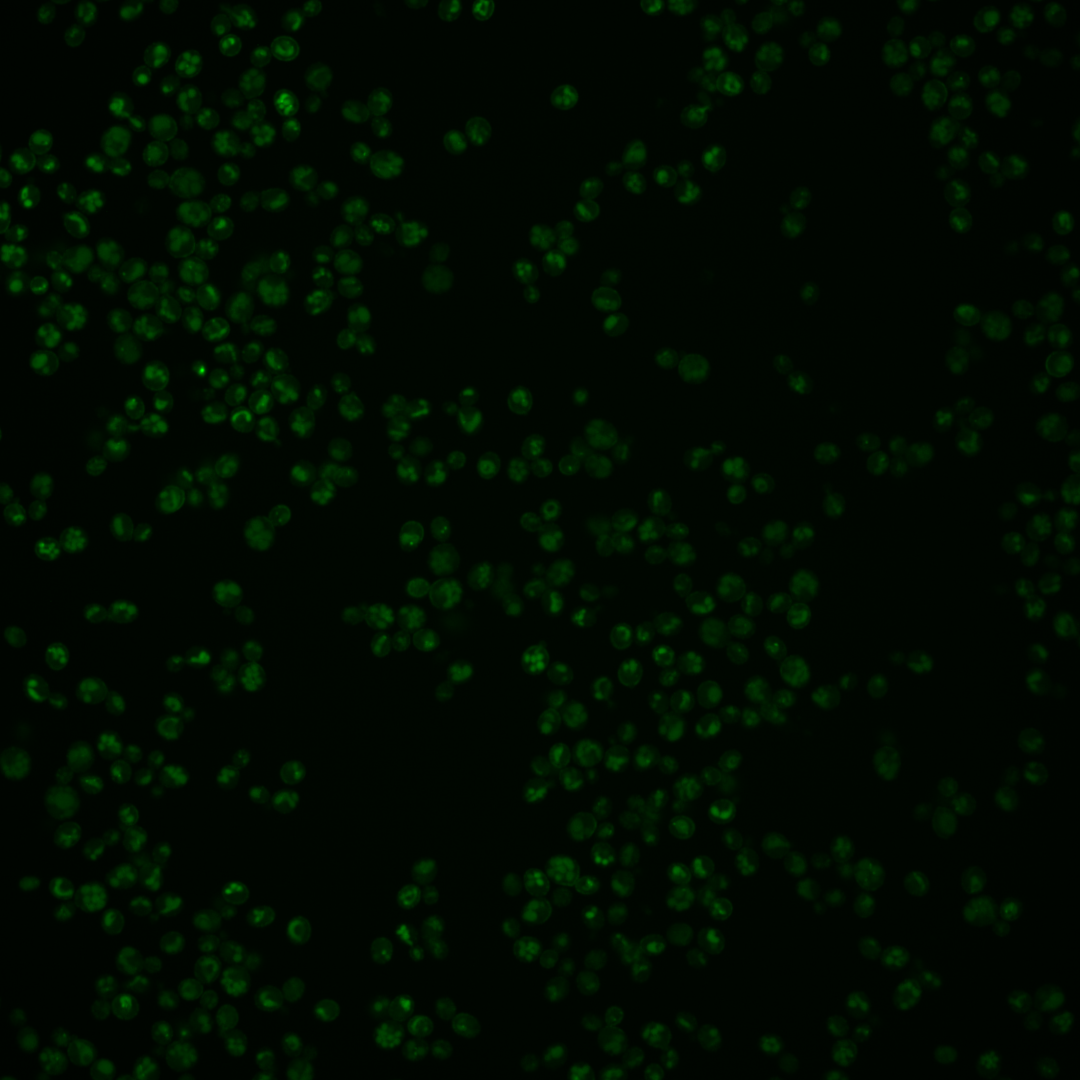
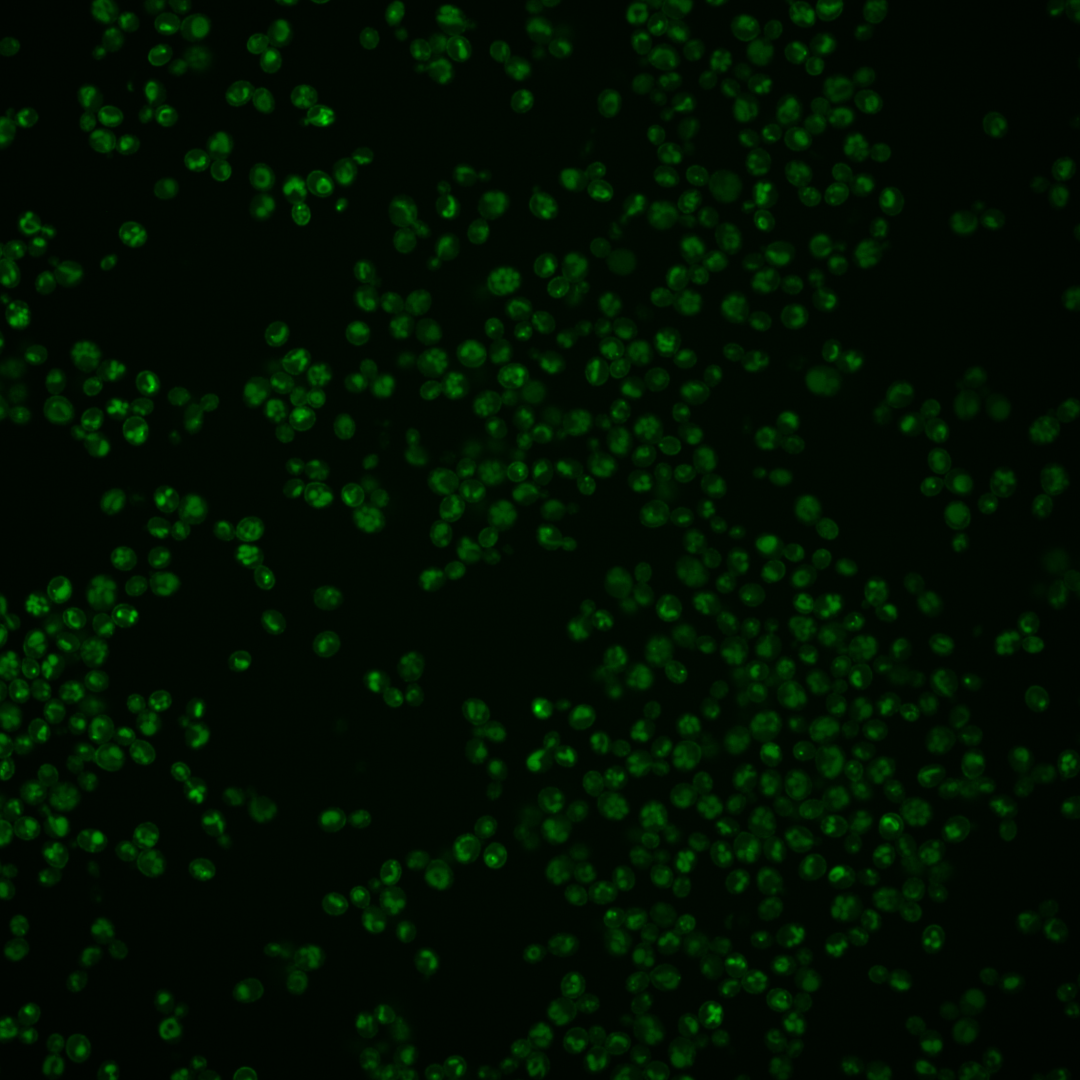
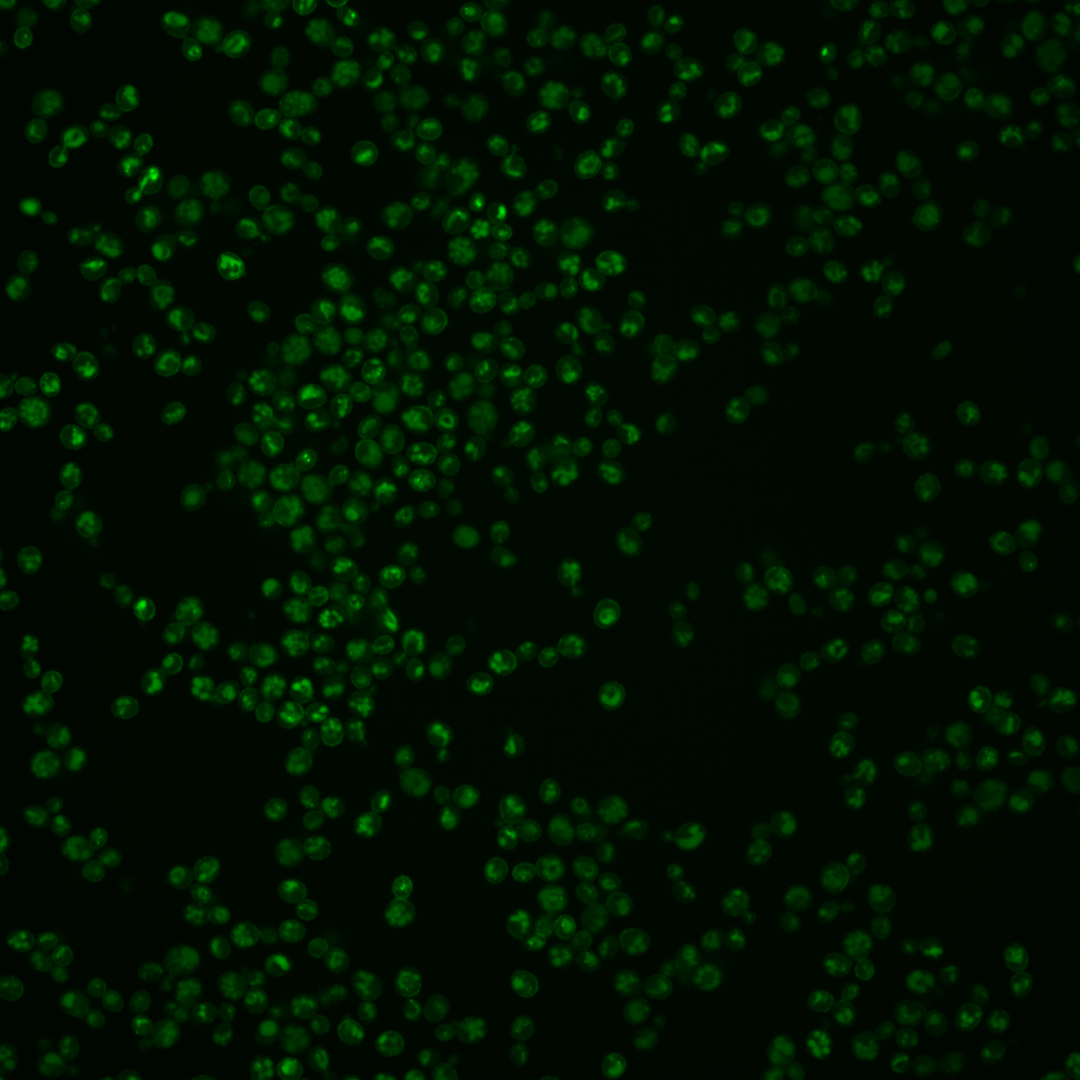

| Standard name | |
|---|---|
| Human Ortholog | |
| Description | Receptor for alpha-factor pheromone; seven transmembrane-domain GPCR that interacts with both pheromone and a heterotrimeric G protein to initiate the signaling response that leads to mating between haploid a and alpha cells |
Micrographs




















































































Sub-cellular Localization
Yeast GFP Assignment
Protein Abundance
Localization Change
External localization resources
| ensLOC | DeepLoc | |||||||||||||||||||||||
|---|---|---|---|---|---|---|---|---|---|---|---|---|---|---|---|---|---|---|---|---|---|---|---|---|
| Localization | WT1 | WT2 | WT3 | RAP60 | RAP140 | RAP220 | RAP300 | RAP380 | RAP460 | RAP540 | RAP620 | RAP700 | HU80 | HU120 | HU160 | rpd3Δ_1 | rpd3Δ_2 | rpd3Δ_3 | WT1 | WT2 | WT3 | AF100 | AF140 | AF180 |
| Cortical Patches | 2 | 1 | 4 | 4 | 2 | 4 | 2 | 0 | 2 | 0 | 2 | 2 | 17 | 22 | 22 | 0 | 0 | 0 | 0 | 0 | 6 | 0 | 0 | 0 |
| Bud | 0 | 0 | 0 | 1 | 0 | 1 | 1 | 2 | 0 | 1 | 0 | 0 | 2 | 1 | 3 | 0 | 0 | 0 | 2 | 0 | 3 | 1 | 1 | 5 |
| Bud Neck | 0 | 0 | 0 | 0 | 0 | 0 | 0 | 0 | 0 | 0 | 0 | 0 | 0 | 0 | 0 | 0 | 0 | 0 | 0 | 0 | 0 | 0 | 0 | 1 |
| Bud Site | 0 | 0 | 0 | 0 | 0 | 0 | 0 | 0 | 0 | 0 | 0 | 0 | 0 | 0 | 0 | 0 | 0 | 0 | – | – | – | – | – | – |
| Cell Periphery | 0 | 0 | 0 | 1 | 0 | 1 | 0 | 0 | 0 | 0 | 1 | 0 | 7 | 1 | 8 | 0 | 0 | 0 | 0 | 0 | 0 | 0 | 0 | 0 |
| Cytoplasm | 6 | 2 | 15 | 9 | 8 | 25 | 29 | 43 | 55 | 46 | 54 | 55 | 11 | 25 | 50 | 6 | 5 | 4 | 2 | 0 | 0 | 0 | 0 | 1 |
| Endoplasmic Reticulum | 7 | 0 | 27 | 14 | 4 | 6 | 3 | 3 | 3 | 0 | 5 | 1 | 75 | 65 | 24 | 2 | 6 | 2 | 9 | 2 | 40 | 0 | 0 | 1 |
| Endosome | 1 | 0 | 1 | 2 | 3 | 14 | 1 | 2 | 1 | 1 | 1 | 2 | 2 | 11 | 22 | 2 | 3 | 2 | 3 | 0 | 1 | 22 | 12 | 29 |
| Golgi | 11 | 0 | 53 | 23 | 15 | 1 | 7 | 3 | 5 | 1 | 0 | 2 | 53 | 62 | 16 | 0 | 0 | 2 | 4 | 0 | 4 | 10 | 6 | 17 |
| Mitochondria | 13 | 4 | 12 | 6 | 14 | 23 | 39 | 48 | 46 | 49 | 60 | 48 | 0 | 2 | 1 | 0 | 4 | 3 | 6 | 0 | 9 | 20 | 37 | 35 |
| Nucleus | 30 | 3 | 27 | 49 | 38 | 91 | 172 | 186 | 72 | 87 | 54 | 71 | 10 | 44 | 45 | 4 | 20 | 9 | 6 | 2 | 0 | 8 | 30 | 16 |
| Nuclear Periphery | 3 | 0 | 2 | 0 | 0 | 6 | 9 | 6 | 4 | 8 | 5 | 6 | 0 | 1 | 2 | 1 | 0 | 0 | 0 | 0 | 2 | 7 | 22 | 35 |
| Nucleolus | 14 | 0 | 11 | 24 | 10 | 22 | 14 | 26 | 8 | 8 | 17 | 17 | 1 | 3 | 6 | 0 | 0 | 0 | 1 | 0 | 0 | 23 | 35 | 28 |
| Peroxisomes | 0 | 0 | 0 | 0 | 1 | 2 | 0 | 0 | 0 | 0 | 0 | 0 | 0 | 0 | 0 | 0 | 0 | 0 | 0 | 0 | 0 | 0 | 0 | 2 |
| SpindlePole | 0 | 0 | 0 | 1 | 1 | 0 | 0 | 0 | 0 | 0 | 0 | 0 | 0 | 9 | 12 | 0 | 0 | 0 | 1 | 0 | 0 | 1 | 1 | 2 |
| Vac/Vac Membrane | 90 | 10 | 171 | 178 | 230 | 333 | 482 | 642 | 344 | 328 | 360 | 381 | 78 | 180 | 141 | 13 | 40 | 27 | 148 | 53 | 249 | 243 | 366 | 338 |
| Unique Cell Count | 145 | 20 | 261 | 263 | 288 | 467 | 692 | 840 | 467 | 460 | 473 | 500 | 206 | 363 | 305 | 25 | 59 | 38 | 190 | 63 | 319 | 343 | 520 | 516 |
| Labelled Cell Count | 177 | 20 | 323 | 312 | 326 | 529 | 759 | 961 | 540 | 529 | 559 | 585 | 256 | 426 | 352 | 28 | 78 | 49 | 190 | 63 | 319 | 343 | 520 | 516 |
Yeast GFP Assignment
Protein Abundance
| Screen | WT1 | WT2 | WT3 | RAP60 | RAP140 | RAP220 | RAP300 | RAP380 | RAP460 | RAP540 | RAP620 | RAP700 | HU80 | HU120 | HU160 | rpd3Δ_1 | rpd3Δ_2 | rpd3Δ_3 | AF100 | AF140 | AF180 |
|---|---|---|---|---|---|---|---|---|---|---|---|---|---|---|---|---|---|---|---|---|---|
| Mean Cell GFP Intensity (1e-4) | 26.0 | 15.0 | 28.0 | 32.7 | 39.5 | 34.2 | 35.0 | 33.0 | 33.8 | 32.4 | 29.4 | 31.9 | 23.0 | 15.5 | 11.6 | 6.1 | 6.6 | 8.1 | 32.5 | 30.7 | 32.1 |
| Std Deviation (1e-4) | 8.9 | 7.1 | 10.6 | 11.3 | 17.5 | 18.0 | 18.5 | 17.8 | 16.8 | 17.5 | 15.6 | 16.5 | 7.4 | 4.9 | 4.2 | 1.2 | 1.6 | 2.1 | 10.9 | 10.9 | 11.6 |
| Intensity Change (Log2) | – | – | – | 0.23 | 0.5 | 0.29 | 0.33 | 0.24 | 0.27 | 0.21 | 0.07 | 0.19 | -0.28 | -0.85 | -1.27 | -2.19 | -2.07 | -1.79 | 0.22 | 0.13 | 0.2 |
Localization Change
| Localization | RAP60 | RAP140 | RAP220 | RAP300 | RAP380 | RAP460 | RAP540 | RAP620 | RAP700 | HU80 | HU120 | HU160 | rpd3Δ_1 | rpd3Δ_2 | rpd3Δ_3 |
|---|---|---|---|---|---|---|---|---|---|---|---|---|---|---|---|
| Cortical Patches | 0 | 0 | 0 | 0 | 0 | 0 | 0 | 0 | 0 | 3.5 | 2.8 | 3.2 | 0 | 0 | 0 |
| Bud | 0 | 0 | 0 | 0 | 0 | 0 | 0 | 0 | 0 | 0 | 0 | 0 | 0 | 0 | 0 |
| Bud Neck | 0 | 0 | 0 | 0 | 0 | 0 | 0 | 0 | 0 | 0 | 0 | 0 | 0 | 0 | 0 |
| Bud Site | 0 | 0 | 0 | 0 | 0 | 0 | 0 | 0 | 0 | 0 | 0 | 0 | 0 | 0 | 0 |
| Cell Periphery | 0 | 0 | 0 | 0 | 0 | 0 | 0 | 0 | 0 | 0 | 0 | 0 | 0 | 0 | 0 |
| Cytoplasm | -1.3 | -1.7 | -0.2 | -1.0 | -0.4 | 2.6 | 2.0 | 2.5 | 2.4 | -0.2 | 0.6 | 4.0 | 0 | 0 | 0 |
| Endoplasmic Reticulum | -2.1 | -4.5 | -5.6 | -7.8 | -8.7 | -6.3 | -7.0 | -5.9 | -7.1 | 6.8 | 2.6 | -1.0 | 0 | 0 | 0 |
| Endosome | 0 | 0 | 2.4 | 0 | 0 | 0 | 0 | 0 | 0 | 0 | 2.4 | 4.1 | 0 | 0 | 0 |
| Golgi | -3.8 | -5.4 | -9.9 | -10.9 | -12.8 | -9.2 | -9.8 | -10.2 | -10.1 | 1.4 | -1.0 | -5.5 | 0 | -3.8 | -2.2 |
| Mitochondria | -1.5 | 0.1 | 0.2 | 0.6 | 0.7 | 2.5 | 2.8 | 3.5 | 2.4 | -3.1 | -3.4 | -3.4 | 0 | 0 | 0 |
| Nucleus | 2.7 | 1.0 | 3.2 | 4.9 | 4.2 | 1.9 | 3.0 | 0.4 | 1.5 | -2.2 | 0.7 | 1.6 | 0 | 4.6 | 0 |
| Nuclear Periphery | 0 | 0 | 0 | 0 | 0 | 0 | 0 | 0 | 0 | 0 | 0 | 0 | 0 | 0 | 0 |
| Nucleolus | 2.3 | -0.5 | 0.3 | -1.9 | -0.9 | -2.0 | -2.0 | -0.4 | -0.6 | -2.5 | -2.8 | -1.6 | 0 | 0 | 0 |
| Peroxisomes | 0 | 0 | 0 | 0 | 0 | 0 | 0 | 0 | 0 | 0 | 0 | 0 | 0 | 0 | 0 |
| SpindlePole | 0 | 0 | 0 | 0 | 0 | 0 | 0 | 0 | 0 | 0 | 0 | 3.2 | 0 | 0 | 0 |
| Vacuole | 0.5 | 3.8 | 1.6 | 1.2 | 3.5 | 2.3 | 1.6 | 3.1 | 3.1 | -5.9 | -4.0 | -4.6 | -1.3 | 0.3 | 0.7 |
External localization resources
Images






























Protein Concentration and Protein Localization Data
| R1 | R2 | R3 | ||||||||||||||||
|---|---|---|---|---|---|---|---|---|---|---|---|---|---|---|---|---|---|---|
| G1 Pre-START | G1 Post-START | S/G2 | Metaphase | Anaphase | Telophase | G1 Pre-START | G1 Post-START | S/G2 | Metaphase | Anaphase | Telophase | G1 Pre-START | G1 Post-START | S/G2 | Metaphase | Anaphase | Telophase | |
| Concentration | 31.6783 | 31.8271 | 28.0587 | 29.1503 | 27.9609 | 29.7961 | 32.9923 | 34.4411 | 27.9314 | 27.2646 | 24.2402 | 30.0409 | 31.1079 | 35.7416 | 33.828 | 27.8262 | 37.1343 | 30.5432 |
| Actin | 0.0062 | 0.0001 | 0.0069 | 0 | 0 | 0.0002 | 0.0197 | 0.0001 | 0.0003 | 0.0001 | 0.0321 | 0.0001 | 0.0059 | 0.0006 | 0.006 | 0 | 0 | 0.0019 |
| Bud | 0.0003 | 0.0002 | 0.0003 | 0.0003 | 0.0003 | 0.0003 | 0.0006 | 0.0005 | 0.0006 | 0.0002 | 0.0016 | 0.0003 | 0.0008 | 0.0006 | 0.0006 | 0.0002 | 0.0003 | 0.0013 |
| Bud Neck | 0.001 | 0.0005 | 0.001 | 0.0008 | 0.0005 | 0.0005 | 0.0019 | 0.0006 | 0.0015 | 0.0004 | 0.0014 | 0.0007 | 0.0008 | 0.0023 | 0.0014 | 0.0007 | 0.0016 | 0.0014 |
| Bud Periphery | 0.0012 | 0.0009 | 0.0013 | 0.0012 | 0.0012 | 0.0014 | 0.0022 | 0.0017 | 0.0029 | 0.0011 | 0.004 | 0.0022 | 0.0025 | 0.0026 | 0.0026 | 0.0008 | 0.0011 | 0.0076 |
| Bud Site | 0.0008 | 0.0005 | 0.0011 | 0.0007 | 0.0004 | 0.0003 | 0.0034 | 0.0021 | 0.005 | 0.0004 | 0.0114 | 0.0004 | 0.0018 | 0.0025 | 0.0017 | 0.0003 | 0.0038 | 0.0012 |
| Cell Periphery | 0.2053 | 0.1547 | 0.1531 | 0.1071 | 0.116 | 0.1441 | 0.2695 | 0.2434 | 0.218 | 0.1968 | 0.1528 | 0.2094 | 0.1875 | 0.169 | 0.1646 | 0.1425 | 0.2132 | 0.1689 |
| Cytoplasm | 0.0019 | 0.0006 | 0.0049 | 0.0005 | 0.001 | 0.0007 | 0.0046 | 0.0009 | 0.0016 | 0.0004 | 0.0013 | 0.0006 | 0.0036 | 0.0005 | 0.0004 | 0.0003 | 0.0004 | 0.0018 |
| Cytoplasmic Foci | 0.0028 | 0.0005 | 0.0007 | 0.0004 | 0.0003 | 0.0005 | 0.0079 | 0.0004 | 0.0042 | 0.0009 | 0.006 | 0.0013 | 0.0102 | 0.0016 | 0.0048 | 0.0009 | 0.0018 | 0.0016 |
| Eisosomes | 0.0003 | 0 | 0.0002 | 0 | 0 | 0 | 0.0004 | 0.0001 | 0.0002 | 0 | 0.0002 | 0 | 0.0003 | 0.0002 | 0.0003 | 0 | 0 | 0 |
| Endoplasmic Reticulum | 0.0021 | 0.0024 | 0.0134 | 0.0004 | 0.0008 | 0.0028 | 0.0051 | 0.007 | 0.0041 | 0.0013 | 0.0022 | 0.0029 | 0.0062 | 0.0028 | 0.0012 | 0.0004 | 0.0004 | 0.0022 |
| Endosome | 0.0103 | 0.0077 | 0.0103 | 0.0058 | 0.0091 | 0.0139 | 0.0123 | 0.0102 | 0.01 | 0.0095 | 0.0348 | 0.0125 | 0.0365 | 0.0221 | 0.0093 | 0.0151 | 0.0179 | 0.0235 |
| Golgi | 0.0011 | 0.0008 | 0.0023 | 0.0003 | 0.0002 | 0.0034 | 0.0034 | 0.0007 | 0.0013 | 0.0009 | 0.0037 | 0.0047 | 0.0157 | 0.0059 | 0.0048 | 0.0006 | 0.0021 | 0.0081 |
| Lipid Particles | 0.033 | 0.0123 | 0.0206 | 0.0329 | 0.0065 | 0.016 | 0.0538 | 0.0191 | 0.0375 | 0.0681 | 0.0511 | 0.0191 | 0.0683 | 0.0256 | 0.08 | 0.0694 | 0.083 | 0.0276 |
| Mitochondria | 0.0055 | 0.0019 | 0.0142 | 0.0008 | 0.0003 | 0.0043 | 0.016 | 0.0115 | 0.0189 | 0.0025 | 0.0215 | 0.007 | 0.0702 | 0.018 | 0.0557 | 0.0007 | 0.0015 | 0.0184 |
| None | 0.0013 | 0 | 0.0003 | 0 | 0 | 0 | 0.0024 | 0.0001 | 0.0036 | 0 | 0.0002 | 0.0001 | 0.0004 | 0.0001 | 0.0001 | 0 | 0.0001 | 0.0001 |
| Nuclear Periphery | 0.0024 | 0.0028 | 0.0031 | 0.0004 | 0.0006 | 0.0016 | 0.0051 | 0.0023 | 0.0023 | 0.0007 | 0.0011 | 0.0014 | 0.0021 | 0.0016 | 0.0008 | 0.0004 | 0.0004 | 0.0013 |
| Nucleolus | 0.0295 | 0.009 | 0.0048 | 0.0099 | 0.0044 | 0.0041 | 0.0077 | 0.0035 | 0.017 | 0.0051 | 0.0195 | 0.0116 | 0.0151 | 0.0185 | 0.0126 | 0.0111 | 0.0316 | 0.0097 |
| Nucleus | 0.0096 | 0.0031 | 0.0025 | 0.0026 | 0.0019 | 0.002 | 0.0025 | 0.0017 | 0.0034 | 0.0014 | 0.0033 | 0.0026 | 0.0043 | 0.0037 | 0.003 | 0.0025 | 0.0033 | 0.0029 |
| Peroxisomes | 0.0005 | 0.0001 | 0.0004 | 0.0001 | 0.0001 | 0.0001 | 0.0033 | 0.0001 | 0.0009 | 0.0001 | 0.0024 | 0.0002 | 0.0035 | 0.0013 | 0.0057 | 0.0002 | 0.0005 | 0.0004 |
| Punctate Nuclear | 0.0008 | 0 | 0.0002 | 0 | 0 | 0 | 0.0027 | 0 | 0.0007 | 0 | 0.0004 | 0 | 0.0015 | 0 | 0 | 0 | 0 | 0.0001 |
| Vacuole | 0.5819 | 0.6791 | 0.6291 | 0.6952 | 0.7642 | 0.6602 | 0.4948 | 0.5852 | 0.5546 | 0.5996 | 0.583 | 0.6179 | 0.4351 | 0.5516 | 0.4746 | 0.6248 | 0.5552 | 0.5984 |
| Vacuole Periphery | 0.1023 | 0.1228 | 0.1293 | 0.1404 | 0.0921 | 0.1437 | 0.0806 | 0.1088 | 0.1113 | 0.1104 | 0.0659 | 0.1052 | 0.1276 | 0.1689 | 0.1698 | 0.1288 | 0.0815 | 0.1218 |
Sequencing Data
| R1 | R2 | |||||||||
|---|---|---|---|---|---|---|---|---|---|---|
| G1 Post-START | S/G2 | Metaphase | Anaphase | Telophase | G1 Post-START | S/G2 | Metaphase | Anaphase | Telophase | |
| Gene Expression | 60.0232 | 39.5768 | 140.0614 | 225.0721 | 91.0691 | 77.4338 | 69.6434 | 111.6684 | 145.7249 | 115.1523 |
| Translational Efficiency | 0.547 | 0.4934 | 0.8881 | 0.5523 | 0.7701 | 0.5996 | 0.4755 | 0.6262 | 0.759 | 0.678 |
Hit Data
| Dataset | Hit |
|---|---|
| Protein Concentration | ✔ |
| Protein Localization | ✘ |
| Gene Expression | ✔ |
| Translational Efficiency | ✘ |
Endocytosis
| Temp | Actin Patch (Sac6-tdTomato) | Cortical Patch (Sla1-GFP) | Late Endosome (Snf7-GFP) | Vacuole (Vph1-GFP) |
|---|---|---|---|---|
| 37℃ | ||||
| RT |
Cell Cycle Omics
CYCLoPs (Ste2-GFP)
| Gene / Allele | Actin Patch (Sac6-tdTomato) | Cortical Patch (Sla1-GFP) | Late Endosome (Snf7-GFP) | Vacuole (Sac6-tdTomato) |
|---|
| Gene | Images |
|---|
| Gene | Images |
|---|
Images are not yet available
Images are not yet available